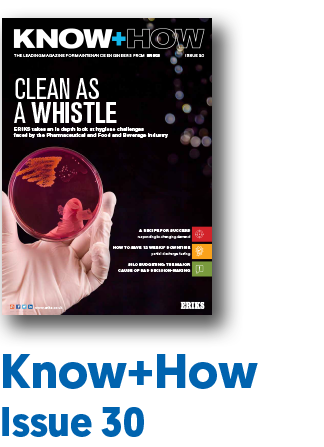
know how issue 30

ERIKS Know+How Magazine
Know+How Magazine is the leading magazine for maintenance engineers from ERIKS. Missed an issue? Then take a look through our back issues...
Know+How Magazine Clean Environments (Issue 51)
ERIKS in Action
Success in sight: Highlights from CEO Pamela Bingham’s first six months.
Having joined ERIKS in October 2023, we look back at Pamela’s journey so far as she understands the business and the people within it. Page 10.
In Focus
SKF names ERIKS First UK Maintenance Partner.
This agreement signifies a deeper commitment beyond transactions, offering customersunparalleled expertise and access to SKF’s cutting-edge technology. Page 28.
Debate
Will AI revolutionise MRO for manufacturers?
As AI continues to evolve could it revolutionise MRO in manufacturing within 2-3 years? Or is there still a long way to go? Page 46.
Know+How Magazine Sustainability & Reliability (Issue 50)
ERIKS In Action
Supply chain report helps businesses improve their performance and reduce downtime.
The ERIKS ‘MRO Supply Chain Report 2024’ delves into the current approaches of UK businesses towards MRO procurement, supply chain and engineering stores. Page 10.
In Focus
How to pluck energy out of the air.
With rising energy costs have you exhausted all common energy saving tactics? Yes? Well, fear not because Festo can help you uncover the savings hiding in your compressed air systems. Page 30.
Debate
Will grid deficiency obstruct electric vehicle adoption?
Is the media reporting on Rishi Sunak’s decision to extend the ban on petrol cars to 2035 a sign of practicality or political manoeuvring? Page 48.
Know+How Magazine Aggressive Environments Issue 49
In Focus
Find the perfect formula for chemicals industry safety.
The chemicals sector poses some of the most high-risk environments to operate within. Ansell and Chemwatch combine to bring you a premium protection package. Page 26.
ERIKS in Action
Made just how you like it.
With a troublesome valve threatening a major manufacturers cappuccino line, ERIKS expertise was called upon to keep that all important caffeine coming. Page 14.
Debate
Will a Royal Commission do what politicians won’t for industrial strategy?
A recent report from MAKE UK offers some interesting findings for a long-term vision of the industrial sector. Is success achievable where others have failed? Or is it just simply a pipe dream?
Know+How Magazine Clean Environments Issue 48
In Focus
Making a clean start in food production
With microorganisms posing a real threat of contaminating machinery, it’s time to call in the cavalry. Armed with compliance, legislation, and engineering knowledge ERIKS deliver peace of mind for your hygienic design. Page 24.
Making Industry Work Better
Say goodbye to the sponge on a stick
The EXPEL Compressed Air Filter, the latest filtration innovation, possesses the capabilities of three conventional compressed air filters in one – could it change the air filtration game? Page 44.
Debate
The EBRS is dead. Long live EBDS?
As one scheme ends and another begins, could the Energy Bills Discount Scheme (EBDS) calm uncertainty across the manufacturing world, or will it add to the difficulty? Page 48.
Latest Issue: No. 47 Sustainability
ERIKS In Action
Walk Less. Run Better. Time really can mean money and when it comes to maintenance every second can impact your balance sheet. An innovative vending solution from ERIKS helped one customer optimise their engineers time, reduce PPE wastage and improve efficiency. Page 10.
In Focus
How thinking in circles saved steel, energy and CO2 The decision to remanufacture vs. replace can offer huge benefits. Eliminating waste, improving lead times, and reducing the impact on the environment. SKF's approach delivers siginificant CO2 and energy savings for one paper manufacturer. Page 24.
Debate
UK Growth: think beyond the sound-bite! Have we fallen victim to seeing only what is right in front of us? Right now, with the focus often being short-term rather than long and the gains that can be made instantly, have we failed to notice the problems associated with short-termism. Page 56.
Back Issue: No. 46 Aggressive Environments with Sustainability Supplement
ERIKS In Action
Industrial Gearboxes: unsung heroes Having rebuilt and refurbished gearboxes since the 1980’s using the most advanced and highest quality components. The new SKF Certified Gearbox Repairer status provides ERIKS independent recognition, so our engineering processes comply with the highest standards. Page 10.
In Focus
How to manage hose management. When it comes to hoses, they can often be overlooked until they fail. Understanding these vital and important components is critical to productivity. We help one steel manufacturer do just that with a hose management solution. Page 16.
Debate
Cost of Living Crisis? Nuclear Fuel Investment vs. Wind Power With a focus on a sustainable and manageable future, the debate continues between Fuel and Wind and which one is best for investment. Could nuclear fuel be left in the shadow of those towering wind farms? Page 46.
Supplement
Building a sustainable future
Just the Sustainability Supplement at your digital fingertips
What is sustainability?
In 1987, the United Nations’ Bruntdland Commission1 defined sustainability as ‘meeting the needs of the present without compromising the ability of future generations to meet their own needs’.
Although this definition remains valid today, the term sustainability has since become associated with a broad range of interconnected issues, from the extraction and use of natural resources, to economic prosperity, education and access to water and food.
The most critical issue, however, is global warming, as human activities that contribute to climate change alter the planet on which we all depend and thus affect our ability to develop a sustainable way of life.
There can be few people who are unaware of the impact of global warming or of the risks that humankind runs if the rate of warming it not brought under control in the coming decades.
Back Issue: No. 45 Hygienic Solutions
ERIKS In Action
Who’s there when the chips are down? The worldwide silicon chip shortage is having a knock on effect across industry with inverter deliveries. Discover how ERIKS delivered an alternative solution to avert a crisis. Page 14.
In Focus
Satisfying the appetite for vegan lubricants Food grade lubricants are more or less standard across the industry. Now ROCOL has become the first lubricant manufacturer to be certified by the Vegan Society. Page 20.
Debate
2022: A Year for Optimism? The past few years have been anything but optimistic for manufacturers and businesses alike. But does 2022 hold the key for a fresh outlook and a new approach? Page 50.
Back issue: No. 44 Reducing Downtime
Reliability – one of the most important qualities a business seeks from its suppliers, its teams, its plant and its products and services. Reliability is the engine that powers industry forward, inspiring confidence and strengthening relationships. It is the key to optimising profitability and the reason why customers return again and again to a trusted source.
In this issue, we’ll be looking at how reliability touches many aspects of productivity and how different industries are building reliability into their operations. Starting with ourselves! In “ERIKS in Action”, we share details of our multi-million pound investment programme into both our engineering services capability and engineering team to become the most effective motor, gearbox and pump repair or replace service in the UK.
Back Issue: No. 43 Aggressive Environments
When you think ‘aggressive environment', what industries immediately spring to mind?’ Our guess is industries such as steel, mining and quarrying, oil and gas where the surrounding environment is particularly harsh.
For ERIKS In Action, we look at unidentified production problems that can hide no more recurring issues cost money. But the introduction of expert online vibration monitoring is the first step to highlighting and removing unidentified production problems.
Our In Focus takes a look at adopting new energy-saving methods that will soon be industry best practices. And what better way to start than by switching to high-efficiency IE4 motors.
Our Debate is asking, are we ready for the reshoring revolution? Although Covid and Brexit have without doubt accelerated the move towards reshoring, there are other long-standing factors that must be considered.
Back Issue: No. 42 Hygienic Solutions
Today, companies are being pushed more than ever to increase their awareness around hygiene, whether that be personal or industry related. So, drawing upon decades of experience, with demonstratable examples from our specialist engineers and partner suppliers, this Hygienic Solutions edition delivers insight and foresight into managing these expectations.
For ERIKS In Action, we look at how we continue to support our customers with their projects, including how our Specialist Engineering team assisted Torpoint Ferry to get back on track, with a large-scale sheave redesign.
Our In Focus takes a look at the stringent regulations around the use of threadlockers and sealants in water applications, and how LOCTITE®’s range of WRAS-approved products eliminate such worries.
Our Debate editorial takes a step outside the box to discuss Donald Trump’s presidential legacy and what we have learned from his four-year reign in office.
Stay informed with ERIKS - tailored to you
Get practical insights, technical expertise, and the latest innovations to help you work smarter and stay ahead.
Subscribe to receive:
- Industry news & updates straight to your inbox
- Know+How Magazine & blog for expert insights and best practices
- Webinars & whitepapers to deepen your technical knowledge
- New products, services & exclusive offers from ERIKS
Choose the topics that matter to you in the ERIKS Subscription Centre.
How to Contact ERIKS
Get in Touch
Looking for a custom Product quote? Need an answer to a Technical question? Looking for Careers/HR support? Want to work with us? Interested in our Digital Trading solutions? Have a finance question? Send us your enquiry and a member of the ERIKS team will be with you quickly.
How are we doing?
We strive to deliver exceptional quality service and products. As part of this goal, we encourage customers to submit feedback on their experiences so we can resolve any issues and concerns.
Call us or find your local Branch
At ERIKS we strive to deliver the best quality service and products. As part of this goal we encourage customers to submit feedback on their experiences so we can resolve any issues and concerns.
Call us: +441215086000